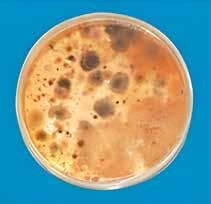

•
•










•
•






they work in harmony to protect, energize, and restore your home—so each sip and every breath supports your

Our Whole-Home Wellness System combines two powerful solutions:
• Structured Living Water – Tastes great, mineral rich, hydrogen infused with optimal cellular absorption.
• Advanced Air Purification – Removes up to 99.9% of allergens, mold spores, bacteria, airborne toxins and surface pathogens creating a fresh and clean environment you can feel in every breath.

As we step into December, I’m reminded of how joy has a way of showing up in the smallest, most unexpected moments—like the sparkle of holiday lights, the smile of a child or a bit of quiet morning reflection before a busy day. Joy doesn’t ask for perfection. It simply invites us to notice—to pause long enough for the heart to catch up with the season.

This month’s issue, “Embrace Joy,” is a celebration of that invitation. It explores how joy can be cultivated not through constant cheer, but through movement, gratitude and connection. In our feature story, “Cultivating Joy: How Movement, Gratitude and Connection Transform Our Lives,” writer Hannah Tytus beautifully illustrates how joy arises in the body, even during the hardest seasons, and how practices like conscious movement help awaken our inner spark.
We’re also shining a light on the extraordinary work happening in our community. In our Community Spotlight, the Central Florida Vitality Reset invites neighbors to reconnect through wellness, music and mindful living—an uplifting way to greet the new year together.
It also shares the story behind Holistic Options Harmony, a center that blends ancient healing traditions with modern diagnostic tools to help individuals rediscover balance and vitality. Founder Mojka Renaud’s vision shows how reconnecting the body’s natural wisdom can lead to profound, lasting wellness.
In this month’s Wellness Expert column, Sean Olenek at Insight Chiropractic offers supportive ways to care for the liver during a season of celebration—gentle reminders that nurturing our organs is another way of nurturing joy with a healthy body.
And as many families gather, our Healing Ways feature, “The Heart Work of Kin-Keeping,” gives voice to the invisible labor that so often holds families together. It’s a compassionate nudge toward sharing responsibilities, reimagining traditions and allowing everyone—especially the family magic-makers—to feel supported.
Of course, no December issue would be complete without something delicious: “The Magic of Gourmet Salts” offers a flavorful adventure, reminding us that even the most ordinary meals can be elevated with intention…and a pinch of something special.
As you make your way through this season—whether it’s busy or quiet, glittering or tender—we hope you find joy in its many forms. Not as something to chase, but as something to welcome.
Warmest wishes for a magical, heart-centered December.

Daralyn & Scott Chase

Publishers, Natural Awakenings Central Florida
P.O. Box 2230 • Winter Park, FL 32790
Ph: 407-628-0705
Publisher@NaturalAwakeningsCentralFlorida.com
NaturalAwakeningsCentralFlorida.com
EDITION
Publishers Daralyn Chase Scott Chase
Writer/Editor Julie Peterson
Design & Production Courtney Ayers
Advertising Scott Chase
Digital Marketing Kristy Mayer
Advocate for Holistic Wellness Casey Fisk & Small Business Growth
Cover image by TAIFUR / Stock.Adobe.com
CEO Kimberly B. Whittle
COO Michael Bevilacqua
CMO Vee Banionis
Sr. VP Operations Brian Stenzler, DC
National Editor Sandra Yeyati
Editor Brooke Goode
Copy Editor Melanie Rankin
Print Production Specialist Kevin Rankin
Design Director Agnes Mazeikaite
Production Flip180
Customer Service Dani Bucad
Natural Awakenings Publishing Corporation
350 Main Street, Suite 9B Bedminster, NJ 07921
Ph: 239-206-2000
NaturalAwakenings@KnoWEwell.com
© 2025 by Natural Awakenings. All rights reserved. Although some parts of this publication may be reproduced and reprinted, we require that prior permission be obtained in writing. Natural Awakenings is a free publication distributed locally and is supported by our advertisers. Some content herein may be partially or wholly produced using AI technology. Please call to find a location near you or if you would like copies placed at your business. We do not necessarily endorse the views expressed in the articles and advertisements, nor are we responsible for the products and services advertised. Check with a healthcare professional regarding the appropriate use of any treatment.











We’ve helped countless people who couldn’t find answers or relief from conventional medicine.
• Lower Back Discomfort
• Migraine Headaches
• Carpal Tunnel Syndrome

• Neck Aches
• Chronic Aches
• Knee Discomfort Cranial Osteopathy & Osteopathic Medicine for Infants, Children and Adults
407.574.2880 11101 W. Colonial Drive • Ocoee, FL 34761 www.RiverOfLifeDO.com


Heartfulness Meditation is a heart-centered approach to meditation that emphasizes connecting with the deeper self and gently moving awareness through the body’s seven chakras—from grounding at the root to expanding at the crown. Each chakra serves a unique purpose in fostering stability, balance and spiritual clarity. Recently, attendees at the Heartfulness Yoga Festival at Orlando’s Lake Eola were introduced to this transformative practice led by members of the Heartfulness Institute.
According to the Heartfulness Institute, Heartfulness Meditation offers “a simple yet profound way to experience the heart’s inner wisdom.” The method combines relaxation, meditation, rejuvenation (or “cleaning”) and prayer, providing a complete framework for personal and spiritual growth. During the Lake Eola event, participants experienced a guided meditation that began with full-body relaxation and settled into deep heart awareness, cultivating peace, focus and emotional grounding.
Through its centers and online programs, the Heartfulness Institute provides free resources and guided sessions for individuals and communities seeking greater balance and inner harmony in everyday life. The practice encourages people to “listen to the heart” and live with compassion, mindfulness and presence.
Heartfulness Meditation is suitable for all experience levels and available both locally and online.
For more information or to join a free meditation session, visit Heartfulness.org or connect with the local Heartfulness Meditation community in Central Florida. Find the Health and Healing you’ve been looking for.

Excited to be a part of The Center for Natural and Integrative Medicine, Poonam Kalidas, MD, combines her expertise in endocrine health with integrative and functional medicine to help patients achieve sustainable wellness. As a board-certified endocrinologist, she focuses on diabetic therapy along with hormones and weight management and approaches all with a passion to find the root cause. Poonam is known for her collaborative, thoughtful style and her commitment to helping patients feel truly heard and empowered. Her clinical interests include thyroid and adrenal health, PCOS, insulin resistance, metabolic optimization and hormonal balance. She integrates conventional endocrine treatments with personalized nutrition, lifestyle interventions and functional diagnostics.
After earning her medical degree from the University of South Florida and completing her internal medicine training at both Emory University and the University of Central Florida, Poonam completed a fellowship in Endocrinology, Diabetes and Metabolism at the University of Florida. Following fellowship, she served as Medical Director of the UF–Halifax Endocrinology Clinic in Daytona Beach, where she led a team recognized for exceptional patient care.
To broaden her impact and adopt a more comprehensive, systems-based approach to healing, Dr. Poonam pursued advanced training through the American Academy of Anti-Aging Medicine and the Institute for Functional Medicine.
Dr. Poonam Kalidas joins the team at The Center for Natural & Integrative Medicine, including Dr. Kirti Kalidas, Dr. Amar Kalidas, Dr. Kushang Shah and Dr. Sara King, who are all committed to exceptional patient care by integrating the latest medical research with both conventional and natural medicine.
For more info, contact The Center for Natural & Integrative Medicine at 407-355-9246 or email info@drkalidas.com. See ad, page 10.






Cassadaga Spiritualist Camp has introduced a Wind Phone to Seneca Park, offering visitors a quiet place for reflection and healing. Set near the park’s waterfall, the vintage rotary phone is intentionally unconnected to any service. Instead, it provides a symbolic way for individuals to “call” loved ones who have passed, speaking aloud as part of their personal grieving process.
The Wind Phone was donated by Lisa Rowell and her family, who lost two of their adult children to overdose. Rowell says the practice has been a meaningful part of their own healing journey and the family is grateful to share that comfort with others who may be navigating loss.
Located on Spirit Pond near Colby Temple at the intersection of Stevens and Marion Streets, Seneca Park now offers this serene addition as a space for remembrance, connection and peace. See ad, page 8.
Central Florida’s holistic community has a new advocate! Casey Fisk has joined the Natural Awakenings Central Florida team, bringing over 15 years of experience in marketing and business development.
As a Board-Certified Holistic Wellness Coach, Fisk blends her love for natural health with her expertise in helping small businesses thrive. For years, she has guided entrepreneurs in building purposeful brands, and now she’s honored to serve the wellness community by connecting like-minded businesses through Natural Awakenings

“I’m passionate about partnering with small businesses that share a mission of helping others feel better, mind, body and soul,” Fisk shares.
Marketing Tip: Consistency builds trust. Whether it’s your message, visuals or posting schedule, people connect with what feels familiar. Keep showing up, and your audience will too.
To explore new ways to elevate your brand and attract aligned clients, connect with Casey Fisk at 407-314-7806 or CaseyFisk@NACFL.com.

The Morgan Center (TMC) is providing a vital service to preschoolage children undergoing cancer treatment by offering a safe, nurturing learning environment that supports cognitive and social development. TMC is a 501(c)(3) notforprofit organization dedicated to making sure children who have suppressed immune systems due to chemotherapy treatments can still engage in formative early childhood experiences.
Founded by Rod and Nancy Lee Zuch, TMC arises from a deeply personal story: their daughter Morgan’s own treatment journey revealed a gap in preschool access for children with cancer. Nancy Lee explains, “When a child is fighting cancer, the everyday milestones like preschool are often stolen away. We created this center so they can laugh, learn and grow even during treatment.” Morgan Zuch, now 27 and declared cancer free since age 10, adds, “I know what they’re going through. The Morgan Center gives children a normal childhood when their world has been turned upside down.”
Operated free of charge for families, TMC’s programming spans socialization, play, early academics and emotional support in a germ-controlled setting. Research shows 90 percent of brain development occurs before age five and missing preschool experiences can lead to long-term behavioral and cognitive challenges.
TMC is sustained entirely by private donations and community fundraising efforts. To help TMC continue to make a difference in the lives of young children battling cancer, simply spread the word to children and families who need help along with spreading the word to individuals, companies or foundations that may like to help the nonprofit through donations or fundraising events.
For more information or to support the mission of The Morgan Center, visit TheMorganCenter.org or call 407-863-0330.



The U.S. Centers for Disease Control and Prevention (CDC) has declared Chagas disease endemic to the United States, meaning that it is consistently present in the country. The disease is transmitted to humans and animals, including cats and dogs, through the feces of blood-sucking kissing bugs. After biting its victim, the bug’s feces deposit the parasite that causes the disease.
The CDC reports that kissing bugs are native to the Southern U.S., but they have been found in 32 states. Chagas disease, which may initially show no symptoms, is a potentially fatal illness that can lead to chronic conditions such as heart failure, an enlarged heart or an enlarged colon. The CDC’s endemic declaration should increase awareness of Chagas disease among doctors and veterinarians, leading to more diagnoses and reporting. The declaration also paves the way for more research investment into improved diagnostics, treatments and prevention.

Undermine the Healthiest Diets
Ultra-processing breaks down whole foods into components and recombines them with additives, flavors, colors and emulsifiers, often making them high in calories, salt, sugar and fat. A 2024 study published in eClinicalMedicine examined the consumption of ultra-processed and minimally processed foods among 200,000 adults with various dietary patterns, including regular red meat eaters, low red meat eaters, flexitarians, pescatarians, vegetarians and vegans. Food frequency questionnaires and food diaries were used to determine diet type and ultra-processed food intake.
Across all diet types, ultra-processed foods made up roughly one-fifth to one-quarter of total daily food intake. Vegetarians and vegans consumed slightly more ultra-processed foods than regular red meat eaters. Low red meat eaters, flexitarians and pescatarians ate modestly fewer ultra-processed foods than regular red meat eaters. All other groups ate more minimally processed foods than regular red meat eaters.


These findings challenge the assumption that plant-based diets inherently contain fewer processed foods. Vegetarian diets included slightly more ultra-processed foods than meat-heavy diets, while diets with modest amounts of meat or fish had the lowest ultra-processed food levels.
The authors noted that plant-based diets vary in quality depending on the degree of processing. While meat and dairy alternatives are often perceived as sustainable, many are highly processed. Simply replacing meat with packaged plant products may not yield the expected health or environmental benefits.

This New Year, Sanford is setting the tone for renewal, connection and vibrant living. On Saturday, January 3, from 11 a.m. to 5 p.m., the streets surrounding WillSol Wellness will come alive for the Inaugural Central Florida Vitality Reset. The public street festival will celebrate health, wellness and community spirit. Admission is free and open to all ages.
Co-hosted by WillSol Wellness and The Sanford Herald, the event will transform 307 East 2nd Street and adjacent downtown blocks into a colorful gathering place filled with local wellness ven dors, guest speakers, live entertainment and healthy food options. It’s a day designed to help Central Floridians start the year inspired, informed and energized.
nutrition specialists and community organizations sharing insights, demonstrations and services designed to support whole-body vitality.
with themselves, their neighbors and their local wellness resources,” says Paul Williams, founder of WillSol Wellness. “Health shouldn’t feel distant or complicated. It should feel like community, like Sanford.”
The Inaugural Vitality Reset is proudly supported by a group of local sponsors who share a passion for holistic living and community connection. Event partners include Natural Awakenings Magazine, West End Trading Co., Celery City Craft, Seacoast Bank, Simmons Counseling, Health in Motion Chiropractic, Order Counter and Nowadays Drinks. Their collaboration underscores the power of unity between small businesses, local media and wellness professionals who believe that thriving communities begin with healthy, connected people. Together, they’re helping make Central Florida a more vibrant place to live, work and grow.

The Central Florida Vitality Reset offers something for everyone — from newcomers exploring wellness for the first time to seasoned health enthusiasts seeking new tools for growth. Attendees will discover a wide variety of holistic practitioners, fitness experts,
Throughout the day, guest speakers will present on topics such as mindfulness, nutrition and stress management, while live music and entertainment fill the streets with energy and joy. When it’s time to recharge, visitors can enjoy local food trucks and beverage vendors offering wholesome and refreshing options that nourish both body and spirit.
“We wanted to create something that brings people together to reconnect
Set amid the charm of downtown Sanford, the Vitality Reset captures the city’s growing reputation as a destination for creativity, culture and conscious living. With WillSol Wellness at its center — a collective dedicated to uniting practitioners and educators — the event is a shining example of what can happen when community and wellness intersect.
Spend the day exploring, learning, and celebrating alongside your neighbors, sponsors, and local wellness community. Because this year, it’s not just about resolutions — it’s about “Resetting. Refreshing. Reconnecting.”
For more information, visit WillSolWellness.com or follow @WillSolWellness on social media. See ad, page 4.
At the heart of Lake Mary, Florida, lies a place where health is treated not as a number on a chart but as a symphony of body, mind and spirit. Holistic Options Inc. has been quietly redefining what it means to feel well for more than three decades. Founded by Mojka Renaud, L.N., A.P., the center has grown into one of the most advanced holistic health-care facilities in the region, rooted in German biological medicine, Chinese medicine and nutritional science.
Renaud’s journey into this field began long before the sleek building and state-of-theart diagnostic devices. Born in Slovenia and raised in Austria, she developed a deep appreciation for herbs and healing plants under the influence of her grandfather, an herbalist. After coming to the United States, she confronted her own health challenges and resolved to seek answers beyond conventional medicine. The result was a mission to provide a true health-care alternative. “My body was my teacher. I knew then that the answers I sought lay not in adding more drugs, but in bringing back the body’s own intelligence,” she says.
Today, the facility serves as a multidisciplinary hub. Clients undergo bio-energetic screening, blood screening, hormone testing along with heavy-metal and food-intolerance assessments. From there the team develops customized programs drawing on nutritional-IV therapy, homeopathy, botanical medicine, colon hydrotherapy, lymphatic-drainage techniques, infrared thermography and organic skin-care protocols. In the spa wing, award-winning organic facial and body treatments using only clean, plant-based products are offered in tandem with deep-healing modalities.
What sets Holistic Options apart is an insistence on being collaborative and evidence-informed. Renaud’s ethos emphasizes
that “the best health-care outcomes come from a partnership between practitioner and client.” To this end, the staff works closely to educate each person on the tools they need to become active participants in their healing. At the same time, the practice remains grounded in measurable, real-world science such as digital thermography for early-detection screening, far infrared saunas, PEMF (pulsed electromagnetic frequency) therapy and water-treatment devices from Japan are all part of the menu.
Clients who arrive seeking relief from fatigue, chronic pain, hormonal imbalance or digestive issues often leave with a new sense of agency. The benefits they report range from enhanced vitality and clearer skin to improved metabolic function and stress resilience. One client who came for unexplained joint pain responded to the integrated approach of heavy-metal testing, lymphatic drainage and botanical support with improved mobility and reduced inflammation. The promise of Holistic Options isn’t a quick fix—it’s a shift in how the body is seen and supported.
A critical piece of the team is Renaud herself, licensed as an acupuncture physician and clinical nutritionist by the State of Florida and certified by the NCCA as a Diplomat of Acupuncture. Supporting her is a rich roster of practitioners, including a certified lymphatic-therapy specialist trained in Europe, a master’s-level clinical nutritionist whose own healing story led her here and a holistic health coach and personal-trainer certified in raw-foods instruction and perception-reframing technologies. This depth of credentialing gives the practice both credibility and human empathy.
Beyond services, the center offers a boutique retail experience, stocked with high-quality superfoods, professional-grade supplements, essential oils, non-toxic home-care

products and EMF-protection devices imported from Europe. This means clients don’t just receive treatments—they walk away with tools to sustain their health.
Looking ahead, Holistic Options is planning an online store to broaden access to its curated products and is developing further educational seminars to empower the community in how to steward health proactively. Renaud envisions a future where preventive, holistic modalities are as routine as the annual physical. “We want to shift the conversation from treating disease to nurturing wellness,” she says.
In a region often inundated with quick-fix promises and one-size-fits-all protocols, Holistic Options stands out for its depth, individuality and longevity. It is, by design, both sanctuary and laboratory, spa and clinic, rooted in tradition yet embracing innovation. For anyone weary of the treadmill of symptom-management, it offers a chance to rewrite the story of their health.
Holistic Options Inc is located at 635 Primera Blvd., Lake Mary, FL. For more information or to schedule, call 407-333-1059 or visit HolisticOptionsInc.com. See ad, page 23.
by Hope R. Clark

Across Central Florida, thousands of young boys are growing up without a steady father figure at home. Nationally, more than 18 million children in the United States live without their biological fathers present. Research shows that these boys face greater risks of school drop-out, incarceration, homelessness and emotional instability.
Vibrant Families (VFAM) launched the Legacy Club Mentoring Program to give fatherless and at-risk boys something many have lacked: consistent mentorship, meaningful structure and hope for the future.
Although VFAM is only three years old, its results have been remarkable. In the nonprofit program’s first year, participating boys demonstrated a 30 percent increase in academic performance and attendance, and a 30 percent reduction in behavioral incidents and violence. Those numbers reflect more than improved statistics—they represent transformed mindsets, renewed self-worth and the ripple effect that a caring mentor can create.

Each month, boys in grades 5 through 12 meet for group mentoring sessions, outdoor activities and one-on-one coaching. They learn practical life skills, leadership habits and tools for emotional management. Outings expose them to new experiences, while mentor relationships model responsibility and healthy masculinity.
VFAM’s founders emphasize that these are not ‘troubled kids.’ They’re capable, intelligent young men who need consistent guidance and belief in their potential. By focusing on accountability, respect and vision, the program helps them see that their past doesn’t define their future.
Founder, Kenneth Cleark, says, “Mentorship transforms absence into opportunity. It gives young men the guidance every heart longs for—someone who says, ‘I see you, and you matter.’”
According to No Longer Fatherless, 71 percent of high-school dropouts come from fatherless homes. Children raised without fathers are also more likely to
struggle with incarceration and substance use. In Florida, more than one-third of families are single-parent households, with most led by mothers.
Research confirms that mentorship changes these outcomes. Boys who have consistent mentors are more likely to graduate, stay out of trouble and build emotional resilience.
VFAM’s early data echoes those findings, showing tangible improvements in both school performance and personal growth.
VFAM’s vision for 2026 is to triple the program’s reach and bring Legacy Club mentoring to more schools and communities across Central Florida. Achieving that goal will require the partnership of corporations committed to lasting social impact.
The most powerful way to support VFAM’s mission is by connecting them with corporate donors who want to create meaningful social-responsibility partnerships. These collaborations allow companies to invest in community development while empowering the next generation of leaders.
By coming alongside VFAM, corporate partners do more than donate—they help build a legacy of strength, hope and belonging that will impact generations to come.
See VibrantFamilies.org for more information. Hope R. Clark is the founder of Pure Hope Wellness, a holistic coaching firm that integrates emotional resilience, faith-based guidance and physical well-being. She is also the Co-Founder of VFAM and serves to strengthen community wellness, leadership development and emotional mastery for students, individuals and corporate teams.

by Sean Olenek, D.C.

The liver is the largest internal organ and the great multitasker in the human body. It helps detoxify the body by removing harmful substances from the bloodstream such as alcohol and toxins; converts nutrients from food into usable energy; stores vitamins, minerals and energy in the form of glycogen; and facilitates the release of bile to assist in breaking down fats and digestion.
Unfortunately, when the liver is not functioning properly, resulting symptoms can range from fatigue, jaundice, swelling, weight gain or even liver disease. The good news is that the liver is also the only organ that can regenerate itself after significant damage.
Between festive meals and busy travel schedules, the liver in your body ends up working overtime, but there are ways to make sure it gets the care it deserves.
Liver health can be improved with chiropractic care. There are nerves extending from the spine that communicate directly with the liver. By balancing the nervous system and improving alignment, chiropractic adjustments enhance blood flow to the liver and ensure that the nerves connected to the liver have clear pathways of communication. Chiropractic care also improves circulation, reduces inflammation, helps the liver function more efficiently and aids in the detoxification process. Adjustments create a better environment for the liver to heal itself.
Another way to improve liver health is through acupuncture. Acupuncture targets energetic systems that play a key role in liver health, promoting balance, which enhances the body’s natural
ability to process and eliminate toxins. Acupuncture improves liver function by reducing inflammation and oxidative stress, improving lipid metabolism and increasing blood flow.
Infrared red light therapy can be combined with acupuncture for additional benefits. Infrared red light therapy supports the body’s natural detoxification systems, including the liver, by improving circulation and oxygenation, reducing inflammation and enhancing cellular function. The deep, penetrating heat from infrared light enhances blood flow and oxygen delivery, both of which are essential for liver function and detoxification. Additionally, infrared red light stimulates mitochondria–“the powerhouse of the cell,” which boosts cellular energy (ATP) production. This boost in ATP gives the liver cells the energy they need to process and metabolize toxins effectively.
You can help detoxify your liver this holiday season by making simple lifestyle choices: take walks after meals, prioritize adequate sleep to give the liver time to repair, stay hydrated, incorporate liver-supportive foods (such as turmeric, ginger and cruciferous veggies) and swap alcohol for festive mocktails.
Keep your liver healthy to experience wide-ranging benefits from the more than 500 functions the liver performs. When you care for your liver, it will care for your whole body.
Sean Olenek, D.C. Insight Chiropractic is located at 1551 Sandspur Rd., Ste. 101 (directly off the I-4 Maitland exit), Maitland, Florida. Hours: Mon to Fri, 8 a.m. to 6 p.m.; Sat, 8 a.m. to 1 p.m. For more information or to schedule, see InsightChiroHealth.com or call 321-926-2997. Specials and discounts are also posted on Facebook: Insight Chiropractic Health and Wellness Center and on Instagram: @insightchiropractic. See ad, page 19.
by Eddie Rivera
In our fast-paced world, rest isn’t simply optional — it’s foundational. At Family Integrative Medicine in Central Florida, rest is viewed not as a passive pause, but as an active healing tool for your heart, hormones, immune system and digestive health. The shift from “go-go-go” to “rest and digest” triggers deeper recovery and balance. Here are easy, daily practices to weave restful rhythm into your life that will help you feel lighter, clearer and more resilient from the inside out.

(5 minutes)
Start your day with intention. Before you check your phone, email or the news, pause and take five slow, deep breaths. Gently stretch your arms above your head, roll your shoulders, loosen your neck and feel your feet grounded. This moment of clarity signals to your nervous system that you’re safe and ready, not rushing or reacting. In doing so you give your body permission to move into parasympathetic mode, which is the state in which healing really happens.
When the demands of the day ramp up, step outside for a short walk. Fresh air, natural light and the simple act of walking reset body and mind. Even ten minutes

can be a reset valve for your stress-response system: the tension eases, your brain clears, your circulation wakes up. Think of it as a mini-break for your nervous system and your spirit or as a way to say, “I matter too.”
Hydration and calm go hand-in-hand. Sip mineral-rich water (and a pinch of sea salt doesn’t hurt) to support your adrenal system. Choose herbal teas like chamomile or lemon balm instead of reaching for caffeine or sugary drinks when you feel frazzled. These gentle choices help your body transition from fight-or-flight into rest-and-digest. When your cells feel nourished, your nervous system relaxes and your digestion, immunity and mood all benefit.


As evening approaches, give yourself a screen-free buffer of 30 to 60 minutes before bed. Power down the devices, dim the lights and allow your nervous system to shift naturally into rest mode. This practice supports better sleep and deeper repair precisely when your heart, hormones and gut are doing the heavy lifting of regeneration.

For those looking to deepen the experience, consider scheduling an acupuncture session, therapeutic massage or guided breathing practice. These therapies help usher your body into its healing state, calming the nervous system and restoring your “rest and digest” rhythm.
Begin small. Choose just one of these practices today. These little steps add up quickly and may be the first step toward reclaiming your life. Giving yourself permission to rest is not indulgence, it is wellness.
Eddie Rivera, MSOM, is a Central Florida health and wellness leader and co-founder of Family Integrative Medicine where patients receive compassionate, evidence-guided functional care dedicated to supporting whole-body wellness. For more information, call 321-284-8839 or visit FamilyIntegrativeMedicine.com. See ad, Page 11.

by Hannah Tytus
Developed by Jennifer Joy Jiménez, TranscenDANCE is a conscious dancing modality that uses gentle movement to connect with the body, release stress and cultivate positive emotion. Here is an abridged practice for daily use.
Step 1: The Dance of Spirit (three minutes)
Begin by bringing awareness to the breath. Listen to the exhale, releasing air slowly and steadily. Root your feet, lift your heart and let your body flow gently, like a leaf in the wind or a cat stretching in the sun. This breathe-and-move practice reconnects you to the present moment and reminds you of your inner calm and strength.
Step 2: The Dance of Shift (three minutes)
Shake it out. Stress lives in the body as tension; release it like flicking water or shaking dust from a rug. Add sound and breath as you move. Each shake helps your nervous system reset, leaving you lighter, clearer and freer.
Step 3: The Dance of Joy (three minutes)
Put on a song that lifts your spirit. Let the body move however it wants— bounce, sway, smile. It’s not about performance; it’s about feeling alive. As gratitude rises from within, joy becomes the natural overflow.
by Hannah Tytus
D“iscovering more joy does not, I’m sorry to say, save us from the inevitability of hardship and heartbreak. In fact, we may cry more easily, but we will laugh more easily, too. Perhaps we are just more alive,” reflected the late Archbishop Desmond Tutu in The Book of Joy: Lasting Happiness in a Changing World , where he shared wisdom alongside the Dalai Lama.
Joy invites us to be more alive. It surfaces through awareness, connection and acceptance of the present moment, exactly as it is. As winter days grow shorter and the year draws to a close, this is a wonderful time to explore what joy truly is, the things that block it and how it can be reclaimed. Ultimately, joy is not a reward for a perfect life, but a way of being that reminds us to embody our full humanity.


Though sometimes fleeting, joy can be profoundly sustaining.
“Joy is much bigger than happiness,” asserted Tutu. “While happiness is often seen as being dependent on external circumstances, joy is not.” This mindset— rooted in both heart and spirit—aligns closely with the Dalai Lama’s vision that genuine fulfillment comes from recognizing the deep interconnectedness of all living beings. Joy is an embodied emotion that is distinct from happiness. Happiness is stable, evaluative and may reflect broader life satisfaction—a contentment with one’s career, finances, family, romantic relationships or personal fulfillment—while joy is experienced in the present moment. It is intense, yet fleeting.
In a study conducted in 2025 and published in the International Journal of Qualitative Studies on Health and Well-Being , researchers interviewed 14 adults about their experiences of joy. The findings explain joy as a complex emotion shaped by individual, relational and cultural contexts. According to the research, joy is intense, transcendent and deeply felt—often arising spontaneously in response to meaningful experiences or connections.
In contrast, happiness encompasses a broader spectrum, exhibiting greater stability, and is associated with life satisfaction and contentment. Participants described joy as a somatic experience, identifying sensations such as “a rush of warmth and lightness throughout the body,” “electricity,” “a bubbling up,” and “tingling sensations,” accompanied by “the urge to move, smile and embrace others.” These
visceral reactions often accompanied moments of intense connection, awe and accomplishment.
If joy is felt through the body, movement itself becomes a doorway to experience it more fully. This cultivation of joy is the cornerstone of Jennifer Joy Jiménez’s life’s work. A pioneer in integrative movement and founder of the Brave Thinking Institute’s Health & Well-Being Division,

“I was in a severe car accident 4 years ago and had lumbar fusion scheduled for early September 2025. After working with Sean for a month and a half, I felt confident enough in my progress that I was able to cancel my lumbar fusion surgery...” -
Tim P.
“The absolute best! Dr. Olenek is very thorough and helps get to the source of the problem. I’ve never had a doctor take so much time and care to help me be the healthiest version of myself. If you’re looking for answers, this is a beyond trustworthy practice.” - Lauren
P.
At Insight Chiropractic Health & Wellness Center, we are committed to helping you achieve optimal health through personalized, holistic care. Our practice is led by Dr. Sean Olenek, an Orlando native with a passion for empowering patients on their wellness journey.






(321) 926-2997 1551 Sandspur Road, Suite 101 Maitland, FL 32751 TAKE
LIFESTYLE. Contact us today at (321) 926-2997 to schedule your appointment. Let us partner with you on your path to wellness.




she developed TranscenDANCE, a conscious dance modality for all ages and mobility levels designed to improve mental, emotional and physical health through inspiring music, body positivity and free-form movement.
Conscious dance is any form of movement that emphasizes mindfulness, inner exploration and emotional release rather than performance or choreography. Although these transformative
movement practices have existed for thousands of years, Jiménez laments that for many Americans, dance may be confined to weddings, occasional outings or fitness classes, leaving little room for the expressive and emotive daily practice that “allows our soul-self to move our human self.”
Jiménez asserts, “Just a few minutes of dancing releases the happy

hormones, offering a DOSE [dopamine, oxytocin, serotonin and endorphins] that shifts our mood better than any antidepressant.” Scientific evidence supports this assertion. A 2024 meta-analysis published in The BMJ analyzed 218 clinical trials, demonstrating that dance was more effective in alleviating depression symptoms than walking, yoga, strength training and even traditional antidepressants.
Joy thrives on connection. While it can arise in solitude, it naturally expands most effectively through relationships and shared humanity. When individuals feel seen, supported and part of something larger than themselves, their sense of well-being deepens.
The 2024 World Happiness Report identifies social support as one of the strongest predictors of life satisfaction. Similarly, the Harvard Study of Adult Development one of the longest-running longitudinal studies of human health—has shown that healthy, fulfilling relationships are the single greatest predictors of both longevity and life satisfaction.
This growing body of research underscores that social connection shapes


health across our lifespan. Individuals that maintain meaningful relationships exhibit lower risks of cardiovascular disease, hypertension, diabetes, infections, cognitive decline and depression compared to those that are lonely. When people share laughter, empathy or a sense of belonging, they exhibit improvements to their nervous system and immune function, as well as an expanded capacity to experience joy.
While connection nurtures joy, disconnection erodes it. In The Book of Joy, the Dalai Lama identified loneliness as one of the most significant obstacles to joy, emphasizing that it arises not from isolation itself, but from a mindset of separation. A person can live alone in the wilderness and still feel content, while another may feel lonely in a crowded room. Loneliness, he suggests, emerges when the heart closes—when anger, fear or stress obscure the ability to perceive warmth in others.
Many modern experiences reinforce this sense of separation. Chronic stress, fatigue, poverty and depression all constrict the emotional space needed for joy. Cultural ideals built around constant happiness add another layer of strain. Researchers describe how placing pressure on ourselves to be perpetually positive leads us to suppress authentic emotion, rather than cultivate genuine
contentment. The Dalai Lama observed that persistent anxiety keeps the mind spinning in worry, unable to rest in presence.
Emotional avoidance further narrows the capacity for joy. According to the 2024 World Happiness Report, individuals that intentionally process difficult experiences report a 40 percent increase in life satisfaction. Gratitude research suggests the reason behind
this phenomenon: Recognizing joy requires openness and receptivity. When individuals soften their defenses and allow life’s full range of emotion, they create space for joy to return.
Adopting an attitude of gratitude is one of the best ways to cultivate joy. Recognized by the Dalai Lama as one of the “8 Pillars of Joy”, gratitude has been shown to enhance the











capacity to perceive joy in everyday life. Gratitude increases joy, and joy, in turn, increases gratitude in an upward spiral of positive disposition. A 2018 study published in The Journal of Positive Psychology revealed that when the participants practiced gratitude regularly, it became part of their natural disposition. Participants that exhibited greater gratitude also experienced heightened levels of joy.
Jiménez notes that cultivating gratitude—and therefore joy—is not just a matter of responding to positive circumstances. “There is a difference between gratitude for and gratitude in. It’s easy to be grateful for positive windfalls like winning the lottery or receiving a nice gift. But when something challenging happens, such as a loved one receiving a serious medical diagnosis, how can we be grateful in

that moment for the gift that lies in the wisdom of that situation?” Viewing challenging events as lessons with the potential for wisdom and healing helps us cultivate a more resilient kind of gratitude.
As Tutu and the Dalai Lama teach, joy is not the absence of struggle but the presence of heart. It lives in the body, grows through connection and deepens through gratitude. To reclaim it, we must soften the grip of perfection, release the myth of constant happiness and allow space for both laughter and tears.
Where infrared sauna and light therapy come together to support detoxification, muscle recovery, skin health, and deep relaxation. Step inside and feel your body restore, reset, and recharge.
*Offer valid for first-time clients only.


Jiménez reminds us that joy is something to be practiced—not achieved—through movement, mindfulness and a willingness to feel. Gratitude becomes the bridge that turns awareness into aliveness, inviting us to notice what was there all along. When people pause long enough to be present, they discover that joy does not need to be sought. It simply needs to be welcomed.
Hannah Tytus is an integrative health coach, researcher and content creator for KnoWEwell, P.B.C., as well as a former writer at the National Institutes of Health.


by Hannah Tytus
Gratitude is an important part of joy be cause it helps us savor life and recognize that much of our good fortune comes from others, including those that have made it possible for us to be ourselves.
Saying Thanks at Mealtime: According to the Dalai Lama in The Book of Joy, even the act of eating a vegetable dish can become a communal experience. Hold gratitude for the seed in the earth, the sunlight and rain that nurtured it, the hands that tended and harvested the plant, the people that trans ported it to the local market or restaurant, and those that prepared the meal or taught us to cook.
Writing Down the Blessings: This dai ly practice is suggested by Jennifer Joy Jiménez, founder of the Brave Thinking Institute’s Health & Well-Being Division. With eyes closed, recall three items from the day for which to be grateful—from a friend’s kindness to the bounty of a good meal or the pleasant aroma in the air. Re cord these items in a journal, aiming to add three new items each day.
The EVOX creates a visual map of a client’s perception about a specific topic such as health, relationships, work, athletic performance, or any aspect of life they would like to improve.
The clients speaks about this topic and the EVOX records the energy of the voice. The voice energy is plotted into a Perception Index, which gives the client a visual image of their perception.
After voice energy is plotted, the client then meditates on the topic until their perception of the topic shifts.
Do you feel weighed down with grief or trauma? Do you face the same challenge every day and wonder Why it seems to always stop you from advancing? Are there phobias that seem to keep you from enjoying your daily life? Have you grown up with hurt or with certain labels placed on you that have hindered you in life? JUST A FEW QUESTIONS TO ASK YOURSELF…..




by Hannah Tytus
The holidays can be a celebration of joy and family time, but for many, they are also a marathon of invisible labor. Someone has to hold it all together, planning meals, wrapping gifts, coordinating visits and meeting everyone’s expectations. Health psychologist Kari Leibowitz, author of How to Winter, notes, “The holidays are when we get wrapped up in shoulds—I should do this, or I’ve always done it this way. But things feel joyful only when the person carrying the load feels joyful, too.” That person managing everything amid the chaos is the family kin-keeper.
In 1985, sociologist Carolyn Rosenthal coined the term “kin-keeping” to describe the often-invisible work of maintaining family bonds: remembering birthdays, organizing holidays,
coordinating visits and keeping everyone connected. A kin-keeper serves as the connective tissue across generations.
Kin-keeping work is rarely assigned; it is quietly assumed across families. The burden falls disproportionately on women, often passing from mother to daughter. Rosenthal’s concept builds on a long history of women’s unpaid labor in the home. Across cultures, someone—usually a woman—has been expected to weave the social fabric, whether through cooking, hosting or mediating family ties. These roles often arose out of necessity but hardened into expectations. This important work demands time, intention and skill. It intensifies during the holidays when meals must be coordinated, gifts tracked and gatherings orchestrated. Even when roles are
unspoken, someone absorbs the relational labor, becoming the family magic-maker.
Kin-keeping is critical for family cohesion. 2023 research published in Sex Roles shows that having a dedicated kin-keeper strengthens intergenerational bonds, encourages rituals and sustains relationships over time. Yet this labor is often unseen, underappreciated and unevenly distributed. Mothers, stepmothers and other female relatives frequently inherit the role, even in blended or post-divorce families. Step-relatives often find themselves bridging fractured family ties, carrying emotional work they never chose—work that can lead to stress, burnout and resentment. Kin-keepers can feel trapped by societal expectations to do it right, even when it hurts.
Reimagining kin work begins by naming it. Recognizing the role and seeing it clearly allows the labor to be set down or shared when it feels heavy or disempowering. To make healthy changes, burdened kin-keepers can ask themselves how they might act from a place of loving intention rather than obligation.
Making invisible labor visible is another key step. Families can talk openly about who does what and acknowledge that sustaining a family is more than cooking meals or paying bills. It is emotional and


relational work. Sharing responsibilities can lighten the load; one person can plan the meal, another take on decorations and a third handle travel logistics. Intentionally involving men and children in tasks helps create a more equitable distribution of labor.
Joy can be reclaimed by letting go of rituals that no longer serve the family, creating new traditions rooted in current realities and needs, and inviting others to co-create meaningful moments. Releasing the need for perfection will also offer relief from stringent responsibilities and create space for simple pleasures and joy. “When people look back on holidays, they rarely remember a perfectly cooked chicken or flawless table setting,” says Leibowitz. “They remember the wreath falling and everyone laughing together. The small, imperfect moments are what last.”
Kin-keeping is powerful because it holds families together. Those that take on this role can be proud of the heart work they do because it is precious. Yet this labor should not come at the cost of one person’s well-being. This season, we can ask what we want to carry and what we can set down. Healing begins by recognizing what was inherited and consciously choosing what to pass on. The magic of the holidays comes alive when care is rooted in fulfillment and agency rather than obligation. Kin-keeping is an act of love— but love does not have to mean doing it all alone.
Hannah Tytus is an integrative health coach, researcher and content creator for KnoWEwell, P.B.C., as well as a former writer at the National Institutes of Health.




• As the main ingredient in your Morning Vitality Elixir. (HoneyMed + Warm Water + Lemon Juice)
• As a sweetener in your tea or coffee.
• On Cheese & Crackers with a glass of Wine
• In a craft cocktail; Drizzled over fruit or in yogurt
• On toasted bread with butter; Mixed in a salad dressing



by Maya Whitman
Specialty salts can transform everyday foods. To elevate the experience, add bold chili salt to a hearty winter stew, smoked salt to popcorn or ruby-colored wine salt to chocolate truffles. Flavored finishing salts surprise the tastebuds in ordinary dishes like oatmeal, desserts or hot cocoa. Used mindfully, gourmet salt reduces the need for excessive sodium and invites us to savor the extraordinary.
“I think salt is amazing and brings out the best in food—all those hidden flavors,” says Craig Cormack, a gourmet salt chef in Cape Town, South Africa. His career as a food artisan advanced in 2009 when he embraced specialty salts. “My personal collection is sitting at 232 naturally occurring salts from around the world,” adds Cormack, who favors unrefined regional varieties, but also enjoys bold options such as smoked Danish Viking salt for its ancient, bonfire-infused qualities.
Salts vary in texture, flavor and nuance based on their source and harvesting techniques, such as solar evaporation or hand-raking. Many contain trace minerals, adding depth to dishes, and when consumed in moderation, sea salt may benefit the body compared to refined salt.
Salt has a bad reputation for causing high blood pressure and other health
conditions, but the U.S. Food and Drug Administration (FDA) states that more than 70 percent of dietary sodium comes from prepared and packaged foods, not from salt added at home. The FDA daily value for sodium is less than 2,300 milligrams per day, and using unrefined salts can be a healthier alternative to common table salt, which is demineralized and processed with anti-clumping
agents. Celtic gray salt and other mineral-rich varieties contain naturally occurring, trace heavy metals, but also minerals like potassium, magnesium and calcium, which can help prevent the body from absorbing harmful metals like lead.
“We all need salt in moderation to live. The best way to ingest salt is to season your own food. Processed food has too much salt, and you can’t control your intake. Naturally made, mineral-rich salt is the best choice,” affirms Nancy Bruns, a seventh-generation salt maker at J.Q. Dickinson Salt-Works, in Malden, West Virginia. She and her family produce rare, small-batch finishing salts harvested from the ancient Iapetus Ocean beneath the Appalachian Mountains.
Whether sourced from evaporated seawater (sea salt) or underground salt mines (rock salt), there is much to


choose from. Sea salt comes in various colors, coarseness and complex flavors. Highly prized flake salt—fleur de sel from coastal France—is hand-harvested from evaporation ponds with clay bottoms and, with its delicate, paper-thin crystals, offers delicious nuances as a finishing salt. Celtic gray salt, sourced deeper within evaporation ponds, contains more moisture and minerals.
Himalayan pink salt, mined from salt beds formed from ancient seas approximately 600 million years ago, contains more than 80 minerals and has a rosy color due to the presence of iron oxide and magnesium. Black volcanic rock salt, also known as Himalayan black salt or kala namak, has a pungent, sulfuric quality that diminishes with heat during cooking and imparts an egg-like aroma and taste that can be useful in vegan recipes. The large, coarse grains of kosher salt traditionally used in Hebrew cuisine give food a robust, briny quality and satisfying texture.
Salt can be infused with herbs, spices, fruits and smoke from various woods to create a multitude of flavor qualities and moods. Bruns highlights her ramp-infused salt, which is combined with wild onions gathered during the Appalachian springtime. Charred oak from old bourbon barrels makes their smoked salt a favorite for grills and even chocolate desserts. Cormack spotlights the fine indulgence of Tartuflanghe brand truffle salt from Italy for an unforgettable mushroom risotto.
Bruns is grateful for the timeless spirit of salt. “I come to work on the same land where my ancestors made salt for over 150 years. I feel their presence, as if they are watching over my shoulder. That legacy and sense of stewardship is present every time I sprinkle salt on my food.”
Maya Whitman is a frequent writer for Natural Awakenings.

1 tsp dried herbs, spices or citrus zest of choice ¼ cup kosher salt, coarse sea salt or coarse Himalayan pink salt
In a bowl, combine 1 teaspoon of dried herbs, spices or citrus zest for every ¼ cup of kosher salt, coarse sea salt or coarse Himalayan pink salt. Stir thoroughly and store the mixture in a sealed, dry, airtight jar. For optimal results, let the flavored salt sit in the closed jar for a few hours before use.
Create a delicious finishing salt for grilled shrimp, vegan tacos or black bean soup by combining 1 teaspoon fresh lime zest, ½ of a dried hot chili pepper and ¼ cup kosher salt. Sprinkle to taste just before serving.
Enhance fresh blueberries, melon, warm oatmeal or freshly baked brownies with a unique flavor by crushing 1 teaspoon of organic lavender buds in a mortar and pestle until the flowers are bruised and fragrant, then combining them with ¼ cup coarse Himalayan pink salt. Sprinkle to taste immediately before serving.
Make a wonderful cooking salt for roasted vegetables by mixing 1 teaspoon dried rosemary with ¼ cup Celtic gray sea salt. Sprinkle to taste before baking in the oven.
Recipe courtesy of Marlaina Donato.








This gourmet holiday dish is ideal for a dinner party.
YIELD: 8 SERVINGS
3½ lbs yellowtail fish, skinned
6½ oz vegetable oil
3½ lbs sliced onions
1 Tbsp garam masala
1 tsp fennel seeds
1 tsp coriander seeds
1 tsp black peppercorns
4 whole cloves
4 to 5 bay leaves
¾ cup, combined, equal amounts of dried apricots and sultanas (golden raisins)
2 cup white or red wine (red wine gives fish a deeper color)
½ Tbsp coarse salt
5 Tbsp white wine vinegar
2 Tbsp brown sugar
Seeds of 1 large pomegranate
FOR HOMEMADE LIME MAYO
5 large egg yolks
1 Tbsp English mustard
Juice of two limes
Preheat the oven to 400° F.
Zest from one lime
1½ cups sunflower oil
1 tsp salt
Place fish in a baking dish, allowing space for sauce.
Heat the vegetable oil in a Dutch oven or a flat wide pot. Add onions, cover and sauté at low heat for 30 minutes, stirring occasionally, until they become sweet.
Stir in garam masala, fennel, coriander, peppercorns, cloves and bay leaves. Turn heat up to medium and fry for 30 seconds to temper the spice, and then add the apricots, sultanas, wine and salt. Reduce heat and simmer uncovered for 20 minutes.
Remove pan from heat and stir in the vinegar and sugar until well incorporated into the sauce. Pour sauce over the fish. Cover baking dish with foil and bake for 20 minutes.
Remove dish from oven, let it cool completely and then refrigerate for at least a day.
Add all the lime mayo ingredients into a bowl, except for the sunflower oil. Slowly add the oil while whisking the ingredients vigorously. When all the oil is added, the mix should be velvety smooth and be able to hold its own shape. Store in the refrigerator.
Serve cold fish on a salad with homemade lime mayo. Garnish with a sprinkle of pomegranate seeds.
Recipe courtesy of Craig Cormack.


Custom built, unique ranch style furniture

Anything made of wood can be given new life or new purpose. Are you the right person to

affordable, honest. Call or email Leo: (407) 252-1894 • aeroleo43@hotmail.com
Be part of our team as we continue grow. If you’re a confident top-performer and looking for a rewarding commissioned sales position, you may be the person we’re seeking for our part-time marketing/advertising consultant position.
Email us to introduce yourself: Scott@NaturalAwakeningsCentralFlorida.com


Wednesday, December 3
Underground Networking Circle for Health & Wellness Professionals, Winter Park – 7-8pm. A monthly after-hours meetup for local health and wellness professionals in Winter Park area. Hosted by Hope Clark and Amanda Charles, this gathering offers a refreshing, intentional approach to networking. Each month, a new host shares their specialty in a brief spotlight, followed by short introductions from attendees. No dues, no referral quotas, just meaningful, word-of-mouth connections. Free. Various offices in Winter Park area. Text “Winter Park” to 386-280-7511.
Friday, December 5
ACU Sound Bowl Therapy – 6-6:45pm. This immersive experience blends the soothing vibration of crystal sound bowls with optional group acupuncture or acupressure, guiding participants into deeper stillness while opening energetic pathways and promoting relaxation and clarity. $30. Insight Chiropractic Health & Wellness, 1551 Sandspur Rd, Ste 101, Maitland. Contact: 321-926-2997. InsightChiroHealth.com.
Saturday, December 6
Christmas Plants w/Jim Hunter – 1011am. Discover the plants that brighten the holiday season, including poinsettias, Christmas cactus and other festive favorites. Learn how to select and care for these seasonal plants while exploring varieties that thrive in Central Florida. This relaxed class offers practical tips for keeping holiday greenery healthy and vibrant. Free. South Seminole Farm & Nursery, 2010 Lake Dr, Casselberry, 407-695-3247, SSeminoleFarmAndNursery.com.
One-Day Healing Intensive – 10am-6pm. Experience a full day of restorative care designed for deep self-renewal in an intimate small-group setting. Participants receive four personalized sessions, including connective tissue massage, lymphatic drainage, aroma touch therapy and hypnotherapy with NLP. The day also features nurturing quiet time, beautiful garden setting, outdoor sauna and cold plunge, and a closing emotional breakthrough session. $485. Address in Maitland provided upon registration. 407-883-7768. Jeebodywork.com.
Holistic Harmony of Yoga and Chiropractic w/Bevalie Pritchard – 2:30-4pm. Join Magnolia Lead Yoga Teacher Bevalie Pritchard and Chiropractor Erin White of Selva Chiropractic for an informative workshop exploring how yoga and chiropractic care complement each other for optimal health. Participants will learn about structural alignment, the mind-body connection and pos-
Central Florida Vitality Reset
2026 1st Annual Community Health & Wellness Festival
Kick off the new year with inspiration and connection at the 1st Annual Central Florida Vitality Reset. Explore the area’s best health and wellness options with expert speakers, local vendors, live entertainment and delicious food and drink. This free community event celebrates new beginnings and holistic living for all ages.
Saturday, January 3 • 11am-5pm Free Admission
307 E 2nd St, Sanford WillSolWellness.com
ture improvement through gentle, restorative yoga combined with expert insight on spinal health and mobility. $22 members, $25 nonmembers. Magnolia Yoga & Wellness Center, 111 West Magnolia Ave, Longwood. Contact: Magnolia Wellness. MagnoliaWellnessCenter.org/Events.
Your Mental Health w/Sharon Gam – 11amnoon. This interactive workshop explores how movement can rewire the brain, lift mood and build confidence. Participants learn how to choose supportive exercise types and intensities, develop movement skills and adapt workouts to enhance mental well-being. Sharon Gam, PhD, an exercise physiologist and certified coach, offers practical tools to feel stronger inside and out. Free. Magnolia Yoga & Wellness Center, 111 West Magnolia Ave, Longwood. MagnoliaWellnessCenter.org/Events.
Underground Networking Circle for Health & Wellness Professionals, Lake Mary – 7-8pm. A monthly after-hours meetup for local health and wellness professionals in Lake Mary area. Hosted by Hope Clark and Amanda Charles, this gathering offers a refreshing, intentional approach to networking. Each month, a new host shares their specialty in a brief spotlight, followed by short introductions from attendees. No dues, no referral quotas, just meaningful, word-of-mouth connections. Free. Various offices in Lake Mary area. Text “Lake Mary” to 386-280-7511.
Prepare for the New Year with Deep Rest and Aligned Intention – 7-8:45pm. This Yoga Nidra workshop invites participants to explore deep rest while planting a personalized intention for the year ahead. The class begins with discussion in the second-floor conference room before moving into the yoga studio for a sleep-meditation practice. Attendees are encouraged to bring note-taking materials and dress in layers for comfort. $30 members, $33 nonmembers. Magnolia Yoga & Wellness, 111 West Magnolia Ave, Longwood. Contact: Magnolia Wellness. MagnoliaWellnessCenter.org/Events.
Friday, December 12
Calm Your Cortisol: Simple Habits to Reset Stress – 6:30-8pm. Learn practical nutrition, sleep and lifestyle tools to support healthy cortisol and steady energy. $10. Serenity Wellness Studio, 123 Main St, Sanford. 407-555-1234. BeWellToday.com.
Saturday, December 13
Cold Protection w/Jim Hunter, Master Gardener – 10-11am. Learn how to safeguard garden plants during cold snaps with practical strategies suited for Central Florida landscapes. The class discusses which plants tolerate colder weather,
Free Spiritual Discourse with Sant Rajinder Singh Ji Maharaj
Experience a free spiritual discourse with Sant Rajinder Singh Ji Maharaj, an internationally respected spiritual master known for his teachings on meditation and inner peace. The program includes guidance on accessing the inner light and sound, along with practical instruction to deepen your meditation practice. Free.
Sunday, January 25 • 3-4pm FREE
Orlando Marriott Lake Mary Mark.Young@sos.org 407-421-7800 • SOS.org
which need protection and simple methods to reduce freeze damage. Ideal for new and experienced gardeners preparing for winter weather. Free. South Seminole Farm & Nursery, 2010 Lake Dr, Casselberry, 407-695-3247, SSeminoleFarmAndNursery.com.
Healing Your Crisis w/Mehta Metaphysical Center – 12:30–2pm. This guided meditation experience supports those feeling overwhelmed, burnt out or stuck in survival mode. Participants are invited to restore balance, release stress and reconnect with a sense of inner peace. Check-in begins at 11:30 a.m. with refreshments and registration. Love donations. Mehta Metaphysical Center, 1 Purlieu Pl, Winter Park. Contact: Mehta Metaphysical Center. MehtaMetaphysicalCenter.com/Events.
Friday, December 19
Holiday Flock Party & Small Biz Showcase – Noon-1:30pm. The Well Adjusted Coop is hosting a family-friendly gathering that celebrates the season with festive activities, local shopping and opportunities to connect with the community. Guests can browse small business vendors, share holiday cheer and create warm memories with loved ones while supporting local makers. Free, free parking. Spaulding Family Chiropractic & Wellness, Inc, 819 E 1st St, Sanford. 407-421-7800. Facebook. com/share/17Nu9aJwW6/.
Saturday, December 20
Silent Book Club – 11am-noon. Join fellow readers for a relaxed, connection-centered gathering where everyone brings their current book. The group begins with brief introductions and sharing what each person is reading, followed by about 35 minutes of quiet individual reading and a short closing discussion. It’s a warm way to build community and enjoy meaningful time with books. Free. Magnolia Yoga & Wellness Center, 111 West Magnolia Ave, Longwood. Contact: Magnolia Wellness. MagnoliaWellnessCenter.org/Events.


Amy’s Sound Meditation w/Mehta Metaphysical Center – 4-6pm. Experience a profound sound meditation in Mehta Metaphysical Center’s Crystal Temple of Global Healing, where the Guardian—a 1,400-pound Rose Quartz Flame—oversees the journey. This immersive experience invites participants to relax deeply, release tension and connect with inner peace through resonant sound frequencies. Pricing: $55 solo/$80 duet with cushioned mats and blankets included, or BYO mat $40 solo/$50 duet. Details: SacredTempleHealingArts.com/ sacred-sound. Mehta Metaphysical Center, One Purlieu Pl, Ste 250, Winter Park. MehtaMetaphysicalCenter.com/events.
Saturday, December 27
Landscape Design w/Judy Halpin – 1011am. Explore fresh ideas for improving your home landscape through thoughtful design. This session covers layout basics, plant selection and ways to enhance the look and function of outdoor spaces. Participants are encouraged to bring questions and receive guidance tailored to their own yards. Free. South Seminole Farm & Nursery, 2010 Lake Dr, Casselberry. 407-695-3247. SSeminoleFarmAndNursery.com.
Sunday, December 28
Vision Board Workshop w/Stephanie Weiss – 3-5pm. Join Reiki Master, yoga teacher and holistic life coach Stephanie Weiss for a soulful afternoon of visual manifestation, energetic alignment and creative flow. The session begins with grounding and gentle chakra activation, followed by intention-setting to welcome clarity and inspiration. Participants then create personalized vision boards infused with authenticity, abundance and purpose for the year ahead. $40 Members, $44 non-members.. Magnolia Yoga & Wellness Center, 111 West Magnolia Ave, Longwood. MagnoliaWellnessCenter.org/Events.
Wednesday, December 31
New Year’s Eve Restorative Yoga + Gong Bath w/Diane Pilatovsky – 6:308pm. Welcome the new year with a restorative practice designed to release tension and invite renewal. Emma Koi guides gentle, supportive postures with a focus on twists, while John Jendro and Diane Pilatovsky offer a gong clearing and balancing experience to reset the energetic field. Together, the session supports clarity, grounding and intention. $32 members, $36 nonmembers. Magnolia Wellness Center, 111 West Magnolia Ave, Longwood. MagnoliaWellnessCenter.org/Events.
Monday
Audubon Park Community Market –5-8pm. Local food and artisan vendors. Live music. 1842 E Winter Park Rd (NW corner of Corrine Dr & Winter Park Rd in Stardust Coffee parking lot). AudubonMarket.com.
Tuesday
Free Magnolia Wellness Hour: The Three Doshas of Ayurveda – 11am-noon. Join Sidney Walters, NAMA Certified Ayurvedic Practitioner, for a free community workshop exploring the three Ayurvedic doshas— the energies that shape body constitution, health and wellbeing. Learn how to identify your unique dosha makeup, recognize when doshas are in or out of balance and apply practices to restore harmony. Space limited. Reg req. Magnolia Yoga & Wellness Center, 111 W Magnolia Ave, Longwood. Reg @MagnoliaWellnessCenter.org/events.
Soothing Yin/Meditation – 6pm. A class that combines breath with longer hold poses for flexibility and to ease stress and anxiety. 75 mins. $20. Sweet Surrender Yoga & Holistic Wellness, 1750 W Broadway St, #112, Oviedo. 786-520-6736. CathrynValorHolisticWellness.com.
Weight Loss Group Hypnotherapy Program w/Marybeth Kritsky – 7-8pm. Lose weight this holiday season while still enjoying the foods you love. This four-week group hypnotherapy program helps participants reset eating habits, feel satisfied with smaller portions, choose healthier foods and boost motivation to exercise. The session offers an easy, enjoyable approach to becoming slimmer and healthier. $149, limited to six. Inhale Light, 1444 Lexington Green Ln, Sanford. 813-586-3210. InhaleLight.com.
Storytellers of Central Florida – 7-8:30pm. 1st Tues. Monthly. Winter Park Public Library, 1052 W Morse Blvd. 407-623-3300. WinterParkLibrary.org.
Wednesday
Downtown Sanford Mom Stroll –8-9:30am. A friendly group of moms meets weekly in downtown Sanford for a relaxed 1.4-mile walk along the lake, ending with playtime for little ones and casual connection time located at Fort Mellon Park. Free. Sanford Pelvic Therapy and Wellness, 307 E 2nd St, Sanford. SanfordPelvicTherapy.com. Reiki Circle w/Inhale Light – 6-7pm. Experience the restorative energy of Reiki in a supportive weekly circle. This gentle, noninvasive session promotes balance and release throughout the mind, body and spirit. Participants connect with universal energy to restore emotional harmony and physical well-being. $30. Inhale Light, 1444 Lexington Green Ln, Sanford. 407-420-3884. InhaleLight.com.
Tai Chi Introductory Class – 6-7pm. Taught by Jim Moltzan, this introductory class will help enhance your range of motion, improve balance and increase strength and flexibility. Open to all ages, it’s a great way to get started with this ancient practice in a supportive environment. Free. Insight Chiropractic Health & Wellness Center, 1551 Sandspur Rd, Ste 101, Maitland. InsightChiroHealth.com. Info@InsightChiroHealth. com. 321-926-2997.
Composing Your Life – Free Series by Gnosis Orlando – 7:30-9pm, starting March 12. Learn to become the conductor of your journey through meditation and self-knowledge techniques. To register, see: GnosticsOrlando@gmail.com.
Thursday
Cosmic Yoga Flow – 6pm. This class combines breath, movement, muscle-toning and balance poses in this gentle Hatha movement class. 75 mins. $20. Sweet Surrender Yoga & Holistic Wellness, 1750 W Broadway St, #112, Oviedo. 786-520-6736. CathrynValorHolisticWellness.com.
Sound Bowl Meditation – 6-6:45pm. Immerse yourself in 45 minutes of deep relaxation while you naturally increase your vibration as the sound bowls emit a miracle tone of healing at a 432-hertz frequency. Bring a mat, blanket, pillow and water. $10. Insight Chiropractic Health & Wellness, 1551 Sandspur Rd, Ste 101, Maitland. 321-926-2997. InsightChiroHealth.com. Facebook:Insight-Chiropractic-Health-and-Wellness-Center.
Free Yoga at Reiter Park – 7:30-8:30am. An all-levels flow class held on the bandshell stage, next to the Longwood Farmers Market. BYO mat and water. Location: 111 W Warren Ave, Longwood. Register at MagnoliaWellenssCenter.org/book-a-class.
Saturday Gardening Workshop Series –10-11am. Free weekly hourlong workshop exploring Central Florida gardening topics—from native plants and seasonal care to pollinator habitats—all led by local nursery experts. Each session offers practical, hands-on guidance to help gardeners cultivate thriving landscapes suited to our region’s climate. Free. South Seminole Farm & Nursery, 2010 E. Lake Dr, Casselberry. SSeminoleFarmAndNursery.com.
Stretch N’ Balance – 10:30am. A practice to tone muscle and build stamina with movement and breath in a series of standing and balance poses. 75 mins. $20. Sweet Surrender Yoga & Holistic Wellness, 1750 W Broadway St, #112, Oviedo. 786-520-6736. CathrynValorHolisticWellness.com.
Free Oncology Yoga – 11am-Noon. A gentle yoga session designed specifically for survivors and their caregivers. Magnolia Yoga & Wellness Center, 111 W Magnolia Ave, Longwood. 407-900-6499.

Make a meaningful impact in your community by becoming the owner of a Natural Awakenings magazine. Empower others with current, valuable insights and resources to enhance their physical, mental, emotional and spiritual well-being.
As a franchise owner, you’ll inspire positive change, provide readers with tools for healthier living and connect local businesses with an audience eager for transformation.
Why Own a Natural Awakenings Magazine?
n Create a Healthier Community: Be the go-to resource for wellness and personal growth in your area.
n Boost Your Income: Take control of your financial future with a proven business model.
n Enjoy a Flexible Lifestyle: Work from home while pursuing a fulfilling, dynamic career.
What We Offer:
n A proven business model with low startup costs.
n Comprehensive training and friendly, ongoing support.
n Flexible work schedule with many work-from-home opportunities.
n Access to a network of like-minded franchise owners.
n Financing Options Available.
Join a thriving network of passionate franchise owners reshaping the future of holistic health and wellness.
Call 239-206-2000 for a FREE evaluation of your community’s potential. Learn more or apply today at: Corp.NaturalAwakenings.com

Own a business that makes a difference.
for a free evaluation of your community's
To apply or learn more, visit Corp.NaturalAwakenings.com.
Add Your Community to Where Natural Awakenings Is Now Publishing:
• Atlanta, GA
• Boston, MA
• Broward County, FL
• Bucks/Montgomery Counties, PA
• Central Florida/Greater Orlando, FL
• Central New Jersey
• Charlotte, NC
• Chicago, IL
• Columbia, SC
• Dallas, TX
• Daytona/Volusia/Flagler Counties, FL
• Detroit/Wayne County, MI
• Fairfield & Southern Litchfield Counties, CT
• Grand Traverse Region/Northern Michigan
• Greater Ann Arbor, MI
• Greater Lansing, MI
• Greater Oakland, Macomb, Livingston, Genesee, MI
• Gulf Coast, Alabama/Mississippi
• Houston, TX
• Jacksonville/St. Augustine, FL
• Lancaster/Berks, PA
• Lehigh Valley, PA
• Long Island, NY
• Milwaukee, WI
• Monmouth/Ocean Counties, NJ
• Naples/Fort Myers, FL
• New York City, NY
• North Central New Jersey
• North New Jersey
• Northwest Florida
• Palm Beach, FL
• Philadelphia, PA
• Rhode Island
• Richmond, VA
• Sarasota, Manatee, Charlotte and DeSoto Counties, FL
• South Central Pennsylvania
• South Jersey, NJ
• Southeast North Carolina
• Space & Treasure Coast, FL
• Tampa, FL
• Tucson, AZ
• Twin Cities, MN
• Westchester/Putnam/Dutchess, NY
• Western Michigan

Connecting you to the leaders in natural healthcare and green living in our community. To find out how you can be included in the Community Resource Guide email Publisher@NaturalAwakeningsCentralFlorida.com to request our media kit.
INSIGHT CHIROPRACTIC
HEALTH & WELLNESS CENTER
Sean Olenek, DC 1551 Sandspur Rd, Ste 101, Maitland 407-565-3085
InsightChiroHealth.com

We provide effective and individualized care for optimal patient outcomes. Our insights come from integrating chiropractic, acupuncture, nutrition, exercise, energy balancing, integrative medicine, functional medicine and alternative medicine. See ad, page 19.
HEALING AMENities
Ingrid and Doug Swailes
407-463-8424

Provides wellness technologies that support cleaner air, purer water, and healthier living. Solutions help relieve sinus issues, allergies, asthma, pet odors, and smoke. Beauty water hydrates and nourishes skin at the deepest level. See ad, page 5.
SOUL WHISPERS
Kaleeya Gabriel
Kaleeya@SoulWhispersLLC.com
SoulWhispers.com

Provides intuitive communication to help people better understand their animal companions. This practice bridges the gap between humans and animals by translating emotions, behaviors and energetic messages to support healing, harmony and deeper connection. Virtual sessions are available.
JLEE BODYWORK
Josh Lee, LMT, CTM
By appointment only/Maitland 407-283-7768

Josh uses the Ida P. Rolf Structural Integration method and Connective Tissue Massage to target the root causes of discomfort. His Ten-Series releases fascia restrictions, enhancing posture, mobility, and body awareness for lasting relief. MM46109 See ad, page 25.
HOLISTIC OPTIONS, INC.
635 Primera Blvd, Lake Mary 407-333-1059
HolisticOptionsInc.com

Digital infrared thermal imaging is a totally non-invasive clinical imaging procedure for detecting and monitoring several diseases and physical injuries, by showing the thermal abnormalities present in the body. It is used as an aid for diagnosis and prognosis, as well as monitoring therapy progress, for conditions and injuries. See ad, page 23.
INSIGHT CHIROPRACTIC HEALTH & WELLNESS CENTER
Sean Olenek, DC 1551 Sandspur Rd, Ste 101, Maitland 407-565-3085
InsightChiroHealth.com

We provide effective and individualized care for optimal patient outcomes. Our insights come from integrating chiropractic, acupuncture, nutrition, exercise, energy balancing, integrative medicine, functional medicine and alternative medicine. See ad, page 19.
BIJOU’S BOUTIQUE
2501 Edgewater Dr, Orlando Mon-Sat 10am-6pm 407-841-9728
BijousBoutique.com

For 30+ yrs, find designer brands and unusual fashion, shoes, accessories and more. With Euro and Caribbean influences, French owner Bijou specializes in natural fibers. We carry sizes XS to XXL. 20% OFF during your birthday month!
David W. Edwards, DMD 541 N Palmetto Ave, #101, Sanford HolisticDentalHealth.com 407-322-6143

Since 2007, I specialize in holistic (biological), cosmetic, mercury-free family dentistry and offer safe amalgam removal. Enjoy our relaxing view overlooking Lake Monroe in Sanford. See ad, page 12.
WINTER PARK SCENIC BOAT TOURS
312 E Morse Blvd (just east of Park Ave) Winter Park 407-644-4056
ScenicBoatTours.com

Tours include 12 miles within the pristine Winter Park chain of lakes. Perfect for office parties and family gatherings. Please call ahead for large groups. Gift certificates available.
DŌTERRA/PURE HOPE WELLNESS
Hope Clark Longwood, FL
719-963-3330
PureHopeWellness.com

Hope Clark, doTERRA Certified Essential Oil Specialist and founder of Pure Hope Wellness, brings over a decade of natural health expertise, leading group trainings and clinical workshops on the effective use of doTERRA’s essential oils.
TACHYON CHAMBER
Orlando • 407-473-6401
Stephanie Ray
TachyonEnergetics.com

Move into the high vibrational energies of Love, Joy & Bliss. This Chamber can address all levels: Physical, Emotional, Spiritual. Our website lists many benefits and pricing. See ad, page 9.
MEHTA METAPHYSICAL CENTER
1 Purlieu Pl, Ste 250, Winter Park 321-203-4688
MehtametaphysicalCenter.com

Host your next event in stunning crystal-infused spaces. Four unique spaces for healing, love, spirit and creativity. Available for hourly rental. See ad, page 39.
HOLISTIC OPTIONS, INC.
635 Primera Blvd, Lake Mary 407-333-1059
FrontOffice@HolistiOptionsInc.com
HolisticOptionsInc.com

Nurture your skin. Restore your balance. Experience our holistic facials or therapeutic massages relax, renew and restore with personalized care designed to support your mind, body and wellness with one-on-one consultation individual customized specialty organic treatment and skin care regimen. See ad, page 23.
AIN’T Y MAMA’S BAKED BEANS
Arlene J. Guffin, Owner Operator AintYoMamasBakedBeans@gmail.com
AintYoMamasBakedBeans.com 407-579-0404

Beaning a Taste of Diversity to Your Table. Come get your bean shot samples! Lady Lake Farmers’ Mkt (Tues 9am-2pm) • Bountiful Farms Mkt (Wed 9am-2pm) • Brownwood Farmers Mkt (Sat 8am-2pm) • Mount Dora Village Mkt (Sun 9am-2pm). Call/txt for special orders.
CHAMBERLIN’S NATURAL FOODS
Alt Spgs/Wekiva 407-774-8866 East Orl/Herndon 407-228-1373
Lake Mary 407-936-9470 Kissimmee 407-846-7454
Lakeland 863-815-0001 Chamberlins.com

For more than 85 years, proudly serving the Central Florida community with organics and local products.
M & M VITAMINS & HEALTH FOODS
118 Middle St (SW corner of Lake Mary Blvd) Lake Mary • 407-330-2666
MandMVitamins.com

Serving CFL since 2006, we may be little, but we are loyal. Get the lowest prices guaranteed on protein powders. Visit our website and sign up for exclusive monthly discounts! Mon-Sat 10am-6pm, Sun 12-4pm.
YOUR HOLISTIC CENTER
Paula White, Nutrition Practitioner
Topher White, Sound Therapist 400 Church St, Ste 101, Kissimmee 407-350-5370 • YHCLife.com

Balancing mind, body and soul through natural therapies including sound healing, ionic detox, tuning forks, chakra cleansing and nutrition needs based on hair analysis to support whole body wellness and holistic healing. See ad, page 21.
FAMILY INTEGRATIVE MEDICINE
982 Douglas Ave, Ste 102 Altamonte Springs 407-751-2192
FamilyIntegrativeMedicine.com

Regenerative medicine, acupuncture, chiropractic, herbal therapy, and physical rehabilitation to address root causes of chronic pain—offering personalized, non-surgical care for lasting wellness. See ad, page 11.
RIVER OF LIFE
11101 W Colonial Dr, Ocoee 407-574-2880
RiverOfLifeDO.com

Provides holistic care through osteopathic manipulation, family medicine, and natural healing, helping patients restore balance, relieve pain and achieve lasting wellness. See ad, page 8.
DR. GLORIA M. SOSA, M.D.
111 W Magnolia Ave, Ste 2012 Longwood • 407-900-6499
LadyMasterNada.Gray@gmail.com LadyMasterNada.com

Certified theta energy and intuitive anatomy healer. Certified spiritual life coach. Healing body level up (HBLU) facilitator. Sacred geometry meditation facilitator. Certified reiki practitioner. See ad, page 9.
Life is a blank canvas, and you need to throw all the paint on it you can.
—Danny Kaye
KIRTI KALIDAS, M.D., N.D.
THE CENTER FOR NATURAL & INTEGRATIVE MEDICINE
6651 Vineland Rd, #150, Orlando 407-355-9246, DrKalidas.com

Dr. Kalidas blends dual medical and naturopathic training to uncover root causes, integrating advanced therapies with compassionate, whole-person care that restores balance, strengthens immunity and supports long-term healing and vibrant wellness. Advanced training in intravenous vitamin-mineral therapy, chelation therapy, ozone, hyperbaric and oxidative medicine. See ad, page 10.
THE CENTER FOR NATURAL & INTEGRATIVE MEDICINE
6651 Vineland Rd, #150, Orlando 407-355-9246, DrKalidas.com

Dr. Kalidas combines osteopathic and functional medicine to uncover root causes of chronic illness, offering thoughtful, data-driven care that supports healing through personalized testing, advanced therapies and collaborative, whole-person treatment plans. Plan may include diet, exercise, vitamins, hormones, supplements, nutritional IV therapy, ozone auto-hemotherapy, hyperthermia heat therapy or prolozone. See ad, page 10.
THE CENTER FOR NATURAL & INTEGRATIVE MEDICINE
6651 Vineland Rd, #150, Orlando 407-355-9246, DrKalidas.com

King bridges advanced clinical expertise with integrative medicine, helping patients uncover the deeper drivers of illness while supporting lasting wellness through personalized prevention, evidence-based therapies and compassionate guidance for every stage of life. Advanced education with the Institute for Functional Medicine and the American Academy of Anti-Aging Medicine. See ad, page 10.
THE CENTER FOR NATURAL & INTEGRATIVE MEDICINE
6651 Vineland Rd, #150, Orlando 407-355-9246, DrKalidas.com

Dr. Shah applies internal and functional medicine to reveal the deeper imbalances behind chronic conditions, offering individualized therapies that support long-term wellness, metabolic health and pain relief through advanced, patient-centered integrative care. Functional medicine training from the Institute for Functional Medicine. Certified in ozone and prolozone therapy. See ad, page 10.
THE CENTER FOR NATURAL & INTEGRATIVE MEDICINE
6651 Vineland Rd, #150, Orlando 407-355-9246, DrKalidas.com

Dr. Kapadia merges advanced endocrine expertise with integrative medicine, uncovering deeper health imbalances and guiding patients toward hormonal harmony, metabolic stability and lasting wellness through attentive listening, personalized care and evidence-informed therapeutic insight. See ad, page 10.
INSIGHT CHIROPRACTIC HEALTH & WELLNESS CENTER
Sean Olenek, DC 1551 Sandspur Rd, Ste 101, Maitland 407-565-3085
InsightChiroHealth.com

Boost healing, reduce inflammation, and support cellular repair with Hyperbaric Oxygen Therapy. This non-invasive treatment delivers pure oxygen in a pressurized chamber to naturally enhance recovery and overall wellness. See ad, page 19.
BEEM LIGHT SAUNA
2305 Edgewater Dr, Orlando 407-203-1721
BeemLightSauna.com

Relax in your own private suite at beem®, where full-spectrum infrared therapy (near, mid and far wavelengths) promotes deep detoxification, boosts circulation, supports calorie burn up to 600 per session and enhances overall wellness from the inside out. See ad, page 22.
PRIME IV HYDRATION AND WELLNESS – WINTER PARK 1844 Winter Park Rd, Ste B, Orlando 407-636-3240

Personalized IV vitamin infusions and injections delivered in a spa-like setting. Their services help restore hydration, boost immunity, enhance recovery, and support overall wellness. From athletic performance to anti-aging, each experience is tailored just for you. See ad, page 11.
LAW OF ATTRACTION LIFE COACH
Life Coach David Phone Coaching 973-444-7301, LifeCoachDavid.com
Certified and experienced. Get the tools and support you need to manifest all you want, feel happier and become the best version of yourself. Once you live your life from a Law of Attraction point-of-view, it only gets better.

MEHTA METAPHYSICAL CENTER
1 Purlieu Place, Ste 250, Winter Park 321-203-4688
MehtametaphysicalCenter.com

Explore the largest metaphysical center in the U.S. 15,000 sqft of crystal galleries, guided meditations, healers, crystal boutique, and event space rentals available. See ad, page 39.
YOUR HOLISTIC CENTER
Paula White, Nutrition Practitioner
Topher White, Sound Therapist
400 Church St, Ste101, Kissimmee 407-350-5370, YHCLife.com

Nutrition Practitioner supporting optimal wellness through personalized plans, nutrition hair analysis and holistic guidance tailored to uncover imbalances, promote healing and help clients thrive naturally from the inside out. See ad, page 21.
SUITE SPACES
1010 Arthur Ave, Orlando
Info@TheSuiteSpaces.com 407-800-1940

No lease hourly rentals for your private practice in Orlando. No leases, no longterm commitments, no buildouts, no furniture costs and no time wasted. Join our community of psychology and wellness professionals and scale your private practice on your terms. See ad, page 20.
SACRED LOVE INSTITUTE
Dr. Virginia Marie Love, CEO & Founder 305-982-7570
Contact@DrVirginiaMarie.com

Internationally known intuitive specializing in relationships, sacred sexuality and trauma recovery. Offers confidential phone sessions and Ericksonian hypnotherapy, addressing everything from infidelity to sexual concerns with compassion where no subject is off-limits.
Recognizing that you are not where you want to be is a starting point to begin changing your life.
~Deborah Day
JOANNE HARRIS MONROE
LPT Realty
1400 International Pkwy, Lake Mary MonroeJH@Outlook.com 689-500-1568, RealtorJHM.com

I’m passionate about helping clients find their dream homes and achieve real estate goals with personalized service. Local expertise and a seamless, enjoyable experience at LPT Realty.
2305 Edgewater Dr, Orlando 407-203-1721
BeemLightSauna.com

Relax in your own private suite at beem®, where full-spectrum infrared therapy (near, mid and far wavelengths) promotes deep detoxification, boosts circulation, supports calorie burn up to 600 per session and enhances overall wellness from the inside out. See ad, page 22.
450 N Lakemont Ave, Ste A, Winter Park MassageTherapy.cc 407-673-6776

Take a tour and enroll for the upcoming March 2025 session. Our graduates quickly become certified with our comprehensive programs. This school also offers discounted massage therapy appointments for readers who apply in advance.
Local to Central Florida and Online 407-595-3731
HolisticLivingSchool.org

Herbalist training, workshops, classes and continuing education units (CEUs) available. Live in-person and online, plus an entire catalog of on-demand classes.
THE PROFESSIONAL SHOE REPAIR, INC.
Luis Restrepo 407-767-8118

Located inside the Altamonte Springs Mall on the lower level west of JC Penney, I repair all types of shoes, sandals, handbags and clothing alterations. Call for hours. Sometimes I can complete while you wait!
TS SKIN CARE
1520 Edgewater Dr, #A, Orlando Mon-Sat: 9am-6pm • Sun: By Appt Only 407-999-5008, TSSkinCare.com

For over 20 years, we formulate our own natural products and offer a variety of skin care services. We also specialize in acne treatments and deep pore cleansing. Visit our website and sign up for discounts!
CASSADAGA SPIRITUALIST
CAMP & BOOKSTORE
1112 Stevens St, Cassadaga (GPS city: Lake Helen) 386-228-2880, Cassadaga.org

Established in 1894, our community has mediums, healers, classes, workshops, tours and events year-round. Seekers are welcome and self-exploration is encouraged. Check out our large spiritual book & gift store. More info on website. See ad, page 8.
MEHTA METAPHYSICAL CENTER
1 Purlieu Pl, Ste 250, Winter Park 321-203-4688
MehtametaphysicalCenter.com

Explore the largest metaphysical center in the U.S. 15,000 sqft of crystal galleries, guided meditations, healers, crystal boutique and event space rentals available. See ad, page 39.
JLEE BODYWORK
Josh Lee, LMT, CTM
By appointment only/Maitland
407-283-7768

Josh uses the Ida P. Rolf Structural Integration method and connective tissue massage to target the root causes of discomfort. His ten-series releases fascia restrictions, enhancing posture, mobility, and body awareness for lasting relief. MM46109. See ad, page 25.
BALANXED LIFE
903-572-0567
BalanxedLife@gmail.com
BalanxedLife.com

Water structuring device for the entire home and a portable solution. Plant based, energy infused wellness products—Electralife, Alkalife, Biotic-Life—designed to revitalize hydration, enhance vitality and simplify natural living.
CENTRAL FLORIDA THERMOGRAPHY
1555 Howell Branch Rd, Ste B-2 Winter Park
407-622-9090
CFLThermography.com

Safe, no-contact, no-radiation thermography exams. Interpreted by Certified MD Thermologists. Offering breast, half body and full body scans. Early detection is key!
FLORIDA MEDICAL THERMOGRAPHY
June Drennon, CCT 2008 727-729-2711
FloridaMedicalThermography.com

Certified Clinical Thermographer 2008. Mindful wellness with thermography! Knowledge is power. Know your risk factors to make corrections and avoid developing pathology. Call for location convenient for you.
635 Primera Blvd, Lake Mary
407-333-1059
HolisticOptionsInc.com

Digital infrared thermal imaging is a totally non-invasive clinical imaging procedure for detecting and monitoring several diseases and physical injuries, by showing the thermal abnormalities present in the body. It is used as an aid for diagnosis and prognosis, as well as monitoring therapy progress, for conditions and injuries. See ad, page 23.
Meetup.com/VegetariansCF CFVegFest.org

We are a non-profit, volunteer-run organization. Since 2005 we have hosted monthly potlucks and special events, including the annual CFL Earth Day Festival & VegFest. Sign up to receive notices for future events. All are welcome!
BALANXED LIFE
903-572-0567
BalanxedLife@gmail.com
BalanxedLife.com

Water structuring device for the entire home and a portable solution. Plant based, energy infused wellness products—Electralife, Alkalife, Biotic-Life—designed to revitalize hydration, enhance vitality and simplify natural living.
Doug and Ingrid Swailes
407-463-8424

Provides wellness technologies that support cleaner air, purer water, and healthier living. Solutions help relieve sinus issues, allergies, asthma, pet odors and smoke. Beauty water hydrates and nourishes skin at the deepest level. See ad, page 5.
SERENITY CENTER AND COMMUNITY SPACE
2040 Winter Springs Blvd, Oviedo Cassandracurley@aol.com 407-719-8883, SerenityCenter.com (MM# 13024)

Our nurturing environment promotes and supports health, well-being and commUNITY. We offer massage therapy, acupuncture, skin care, counseling and more. Space is also available for workshops and special events.
HANDCRAFTED BY LHH
Experienced, affordable, honest. Call or email Leo: 407-252-1894 • Aeroleo43@hotmail.com

Looking to Refurbish, Repurpose, or Repair Anything Made of Wood? Anything made of wood can be given a new life or new purpose. See ad, page 29.
SWEET SURRENDER YOGA & HOLISTIC WELLNESS
Cathy Valor
1750 W Broadway St #112, Oviedo 786-520-6736
CathrynValorHolisticWellness.com

Discover a brand-new studio that offers tranquil-enhancing yoga, tai chi, sound bowl and day spa services. Studio rental with a kitchen is available for various get-togethers and small weddings.





“An imbalanced brain is one that reacts from the past… everything is a
to actually have a chance to harmonize itself, allows a person to respond in the present moment instead of being triggered by the past.”

